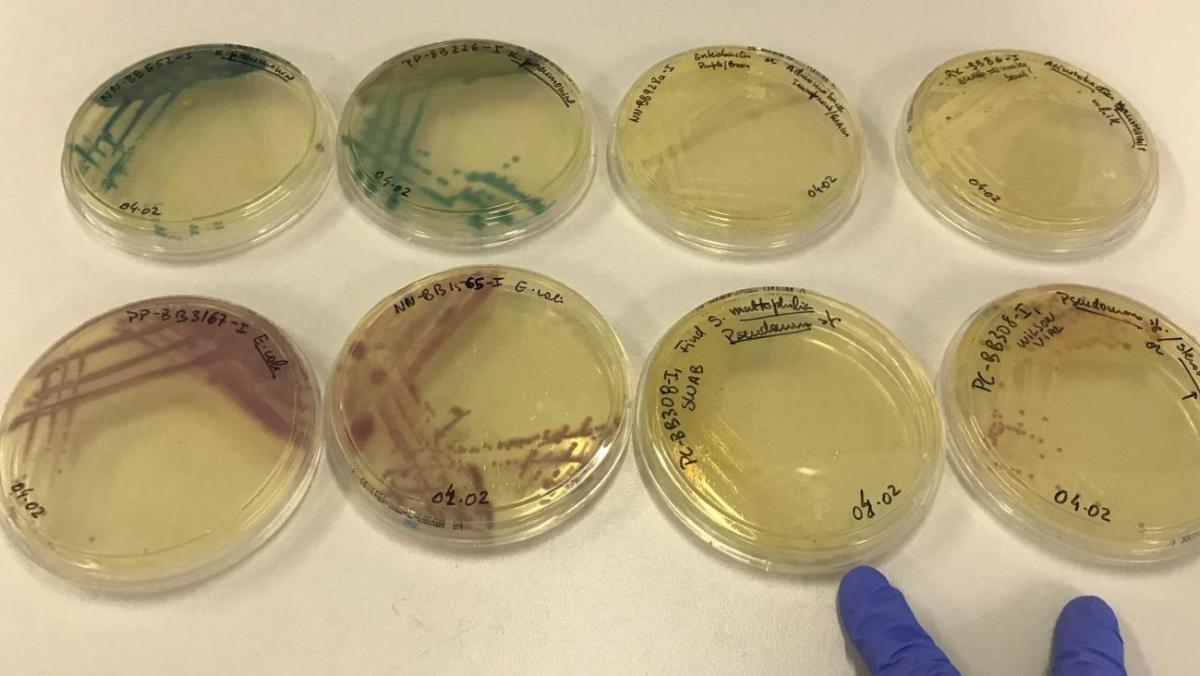

World Sepsis Day 2025: fighting twin challenges of sepsis and AMR
Sepsis affects up to 50 million people every year, and causes 20% of all global deaths. Antibiotics are the primary treatment for sepsis, however growing rates of antimicrobial resistance (AMR) make sepsis infections harder to treat, leading to higher mortality rates.
Without effective treatment sepsis can lead to septic shock, organ failure and death. Low- and middle- income countries (LMICs), particularly in sub-Sahara Africa and South Asia carry the highest clinical AMR burden; however, data is sparse.
Bacterial samples in IOI's laboratory
To address this paucity in data, the Ineos Oxford Institute for antimicrobial research (IOI) has established a network of 28 hospital and clinics across 7 countries. This network supports two studies – sepsis in adults and sepsis in newborns. The IOI also supports capacity strengthening including laboratory refurbishing, equipment supplies and education material.
Doctors and nurses from our partner hospitals collect blood samples from patients with suspected sepsis and process the samples locally. Bacteria from patients with confirmed infections are also sent to the UK and analysed in our labs at the IOI to understand the dominant pathogens causing the sepsis outbreaks and how resistant they are to locally available antibiotics. This information is quickly shared with the IOI hospital network.
The IOI, has a particular focus on neonatal sepsis where the mortality is unacceptably high. Recently researchers found evidence of bacteria carrying antibiotic resistance genes in hospital surfaces such as sinks, medical equipment and ward furniture in six LMICs. These bacterial species included Klebsiella pneumoniae and Acinetobacter baumannii, which can cause pneumonia, urinary tract infections and blood infections, and can pose significant risk of hospital acquired infections to new-born babies and patients in hospitals.
Currently there are evidence gaps and implementation challenges in existing IPC guidelines that aim to prevent and control colonisation of these bacteria. The findings from this study will help hospitals to improve infection prevention and control measures to prevent the spread of diseases such as sepsis.

Working with hospitals has given us insight into the challenges they face implementing good cleaning and disinfection measures. There are limited resources, sometimes without running water and staff are extremely stretched, with high numbers of patients. We have used our observations over the last ten years to improve and guide the next phase of our research, gathering more comprehensive data to help tackle these problems.

A recent Nature Communications study showed an IOI research project in Nigeria reduced newborn deaths by identifying that the first line antibiotic treatment of ampicillin and gentamicin was ineffective in treating newborn babies with neonatal sepsis. The study supported new diagnostic tools, recruitment of additional clinical staff, and construction of new laboratories. This led to early detection and treatment of sepsis in new-born babies.
Dr Kenneth C. Iregbu, co-PI of the study at the National Hospital Abuja, Nigeria recognised, “This discovery helped save many lives and will continue to do so even after the study ends.”
In many low- and middle-income countries, clinicians are forced to treat infections without access to laboratory confirmation, leading to overuse or misuse of antibiotics. All our findings to date underscore the important of AMR surveillance projects to guide development of appropriate treatment plans and infection prevention and control guidelines to mitigate antibiotic resistance.

World Sepsis Day is a reminder that addressing sepsis means confronting AMR, two interconnected challenges that require global action and continued collaborative research to save lives.
Find out more about IOI’s work in tacking blood stream infections:
